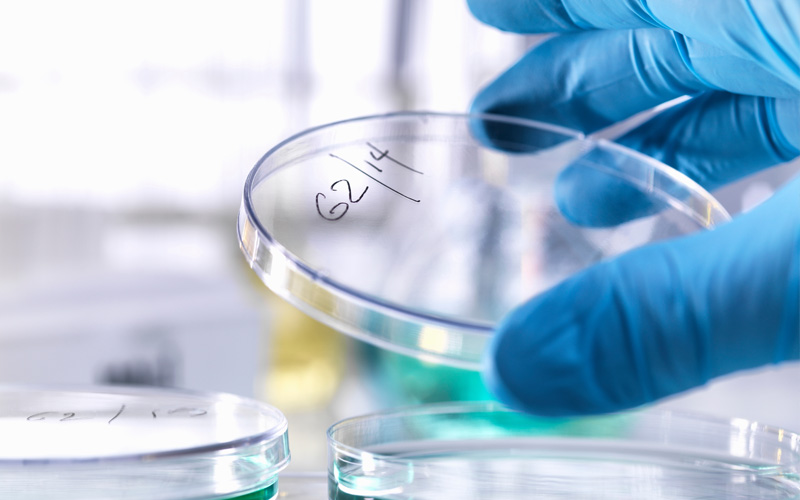

ABOUT
Avista focuses on investing in and growing healthcare companies. Our deep industry expertise and proactive value-added investment approach creates enduring partnerships with our portfolio companies.
We were founded in 2005 as a spin-out from DLJ Merchant Banking, which at the time was one of the world’s largest and most renowned investment firms. We believe we have built a world-class private equity firm focused on the healthcare industry. Our long tenure in the market leads to a deep understanding of the micro and macro trends driving value and opportunity within the healthcare sector.
Disciplined focus on stable healthcare assets where Avista’s sector expertise can drive accelerated growth
Over $8 billion invested in over 45 healthcare companies
Supported more than 100 add-on acquisitions
Leadership team has invested together for nearly 3 decades in the healthcare sector
25 investment and operations professionals
10 Healthcare Strategic Executives

